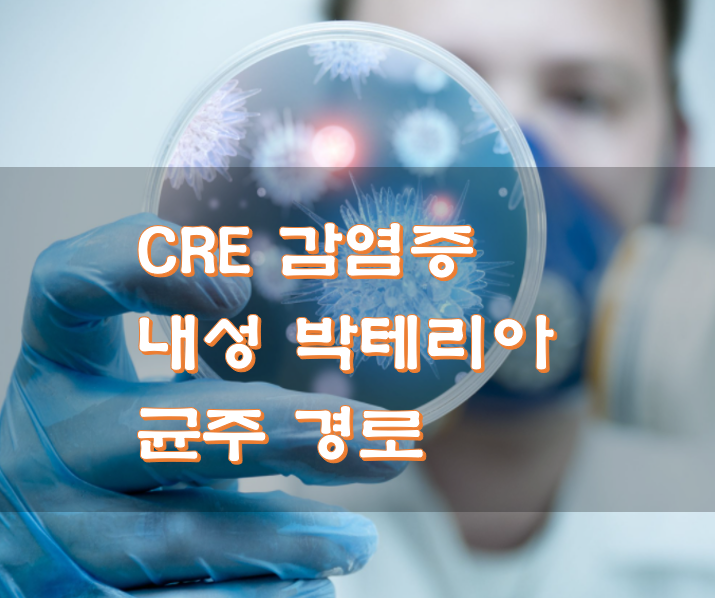

CRE 감염증 내성 박테리아 균주 경로
- 건강
- 2020. 11. 6. 13:06
한번쯤은 들어봤을 겁니다. 항생제에 내성이 있는 박테리아 균주에 대해서, 오래전부터 CRE 감염증은 존재 해왔으며, 매년 그 증가세가 높아지고 있다고 합니다. 과연 CRE 감염증과 같은 내성 박테리아 균주의 감염 경로는 어디일까요. 오늘 CRE에 대한 궁금증을 풀어봅니다.
CRE 감염증
아시는 지 모르겠지만 CRE 감염증은 전 세계적으로 그 사태의 심각성을 인지하고 있습니다. 세계 보건기구 who는 우선순위 중요 병원균으로 CRE를 지목했습니다.
카르바페넴 내성 장내 세균과 (carbapenem-resistant enterobacteriaceae)의 약자인 CRE는 다른 항생제가 실패했을 때 심각한 감염을 치료하기 위한 마지막 수단으로 일반적으로 사용되는 항생제 클래스인 카르바페넴에 내성이 있는 박테리아 균주를 말합니다.
CRE 감염은 모든 항생제에 내성을 갖게 되어 치료하기가 어려우며, 매우 치명적이기 때문에 "악몽의 박테리아"라고 이야기하기도 합니다. 해당 CRE균은 일반적으로 병원 또는 요양원과 같은 의료시설에서 면역성이 약한 환자들의 목숨을 위협하고 있습니다.
우리나라 및 외국에도 이와 같은 CRE 박테리아가 증가하는 추세이며, 이웃나라 미국같은경우 CRE 박테리아로 인한 혈류 감염으로 병원 환자의 50%가 사망한다고 하네요. 그만큼 치료하기 힘든 균이라는 것이죠.

CRE 감염 경로 원인
CRE 감염은 의료 전문가가 혈액, 상처에서 나오는 배액, 소변, 대변 또는 가래와 같은 감염된 사람의 체액과 직접 접촉할 때 전파될 가능성이 높다고 합니다. 이와 같은 예로는 간호사가 감염된 환자의 상처를 만진 다음 다른 환자를 만져 두 번째 환자를 박테리아에 감염시킬 수 있습니다.
의외로 병원에서의 감염은 의료 장비나 세균과 접촉 한 오염 된 표면(침대, 계단봉, 유리, 의자)을 만져도 전염될 수 있다고 합니다. 그래서 부모님들이 응급실이 있는 큰 병원에 면역성이 약한 아이를 데려가는 것을 좋아하지 않았나 그리 생각합니다.

단, 건강한 사람들은 일반적으로 CRE에 감염에 큰 위험은 없습니다. 보통 의료시설에 있는 면역성이 많이 약해진 환자들이 CRE감염을 주의해야 합니다. 주로 소변 카테터, 정맥 카테터 또는 인공호흡기 기계, 특정 항생제를 오랜 기간 복용하는 사람들은 특히나 주의해야 합니다.
음 갑자기 생각이 나는데 위내시경, 대장내시경 할때 해당 장비를 잘 세척하지 않으면 혹시나 이런 CRE 감염증과 같은 박테리 균에 문제가 발생하는 건 아니겠죠. 일반적인 사람들은 면역성이 좋고, 그러한 내시경 하는 병원에 그런 균들이 있을지 의문도 드네요. 그래도 청결이 좋은 병원에서 검사받는 게 좋을 것 같아요.


▣ CRE 감염 증상
CRE는 박테리아가 퍼지는 위치에 따라 다양한 질병을 일으킬수 있다고 합니다.
-
혈액감염
-
상처 감염
-
요로감염 및 폐렴
일반적인 감염 증상으로는
-
고열
-
오한
-
부기
-
상처 통증
수술 후 면역성이 약 해지분들이 위와 같은 증상이 있는지 모니터링하는 것도 중요하다고 하네요. 혹 가족 중에서 몸이 좋지 않아 수술과 같은 것을 하게 된다면 꼭 발열, 붓기, 통증, 졸음과 같은 증상이 없는지 확인하는 것도 중요해 보입니다.

▣ CRE 감염증 예방
무슨 질병이든 가장 중요한 것은 예방입니다. 특히 CRE 감염증 예방은 청결이 우선시되어야 합니다. 즉 병원에서는 의료 기기를 사용하기 전에 꼼꼼하게 세척하고 살균해야 하며, 세척 및 멸균된 장치는 깨끗하고 멸균 된 작업 공간을 유지하기 위해 적절하게 훈련된 직원 만이 취급해야 합니다.
이것이 우리가 할 수 있는 것은 집에서 손을 자주 씻고 표면을 소독한다면, 간병인이나 감연자에 의한 CRE 확산을 사전에 예방할 수 있습니다. 또한 항생제의 무분별한 남용은 하지 말아야 하며, 처방전에 있는 그대로 사용하는 것이 중요합니다.
먹다 안 먹다 하지 말고 꼭 항생제를 사용했을 때는 다 치료 될 때까지 끝까지 의사가 처방해준 처방전대로 복용하세요. 이상으로 CRE 감염증 내성 박테리아 균주 경로 포스팅을 마칩니다.
'건강' 카테고리의 다른 글
| 역류성 식도염 증상 가슴답답 (11) | 2020.11.23 |
|---|---|
| 편도결석 증상 원인 예방 (5) | 2020.11.17 |
| 여성 탈모 확인법 원인 빈혈 (9) | 2020.11.12 |
| 귀이명 청력검사 비용 실손 청구 (15) | 2020.11.10 |
| 장내 유익균 프로바이오틱스 유산균 추천 (19) | 2020.10.27 |
| 왼쪽 겨드랑이 아래 통증 (26) | 2020.10.20 |
| 턱근육 떨림 통증 뭉침 이유 (7) | 2020.10.18 |
| 중학생 독감 무료접종 기간 만18세까지 (8) | 2020.10.15 |
이 글을 공유하기






